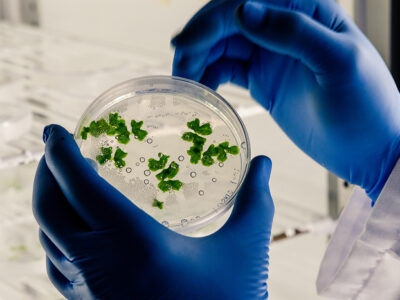
Abonos Cress-Test

20 años generando evidencia científica para decisiones agrícolas de alto impacto
Somos especialistas en análisis para agricultura, acuacultura y agroindustria. Potenciamos tus decisiones técnicas con resultados confiables y rápidos.
Nuestro estándar técnico para garantizar resultados precisos
Soluciones científicas para optimizar su producción agrícola
Cómo preparar y enviar tus muestras
Para garantizar un análisis eficiente y sin retrasos, sigue estos pasos para preparar y enviar tus muestras correctamente.
Instructivos de toma de muestras
Ponemos a tu disposición instructivos oficiales para asegurar una toma y envío de muestras precisa y representativa, fundamentales para obtener resultados confiables.
Blog de Ciencia y Análisis Agrícola
Muestreo foliar
El análisis de tejido foliar permite diagnosticar el estado nutricional de los cultivos; es decir, se evalúa las proporciones de nutrientes que la planta absorbe en sus distintas etapas de desarrollo.
Muestreo del agua de riego
El agua constituye del 60 al 85% de la biomasa de los cultivos de interés agrícola o de sus partes cosechables; mientras que el resto es la materia seca compuesta por diferentes nutrientes.
Muestreo del suelo
Más del 95% de la producción agrícola a nivel mundial depende o se ejecuta en el suelo. Sin embargo, en el sector agrícola todavía se necesita conocer sobre el impacto de las propiedades
Importancia del muestreo
El análisis de suelo, agua de riego y tejido foliar permite optimizar el uso de recursos y mejorar la sostenibilidad de los sistemas agropecuarios. El uso de nuevas tecnologías y la optimización
Control de calidad y precisión
Enfoque integral del sistema productivo